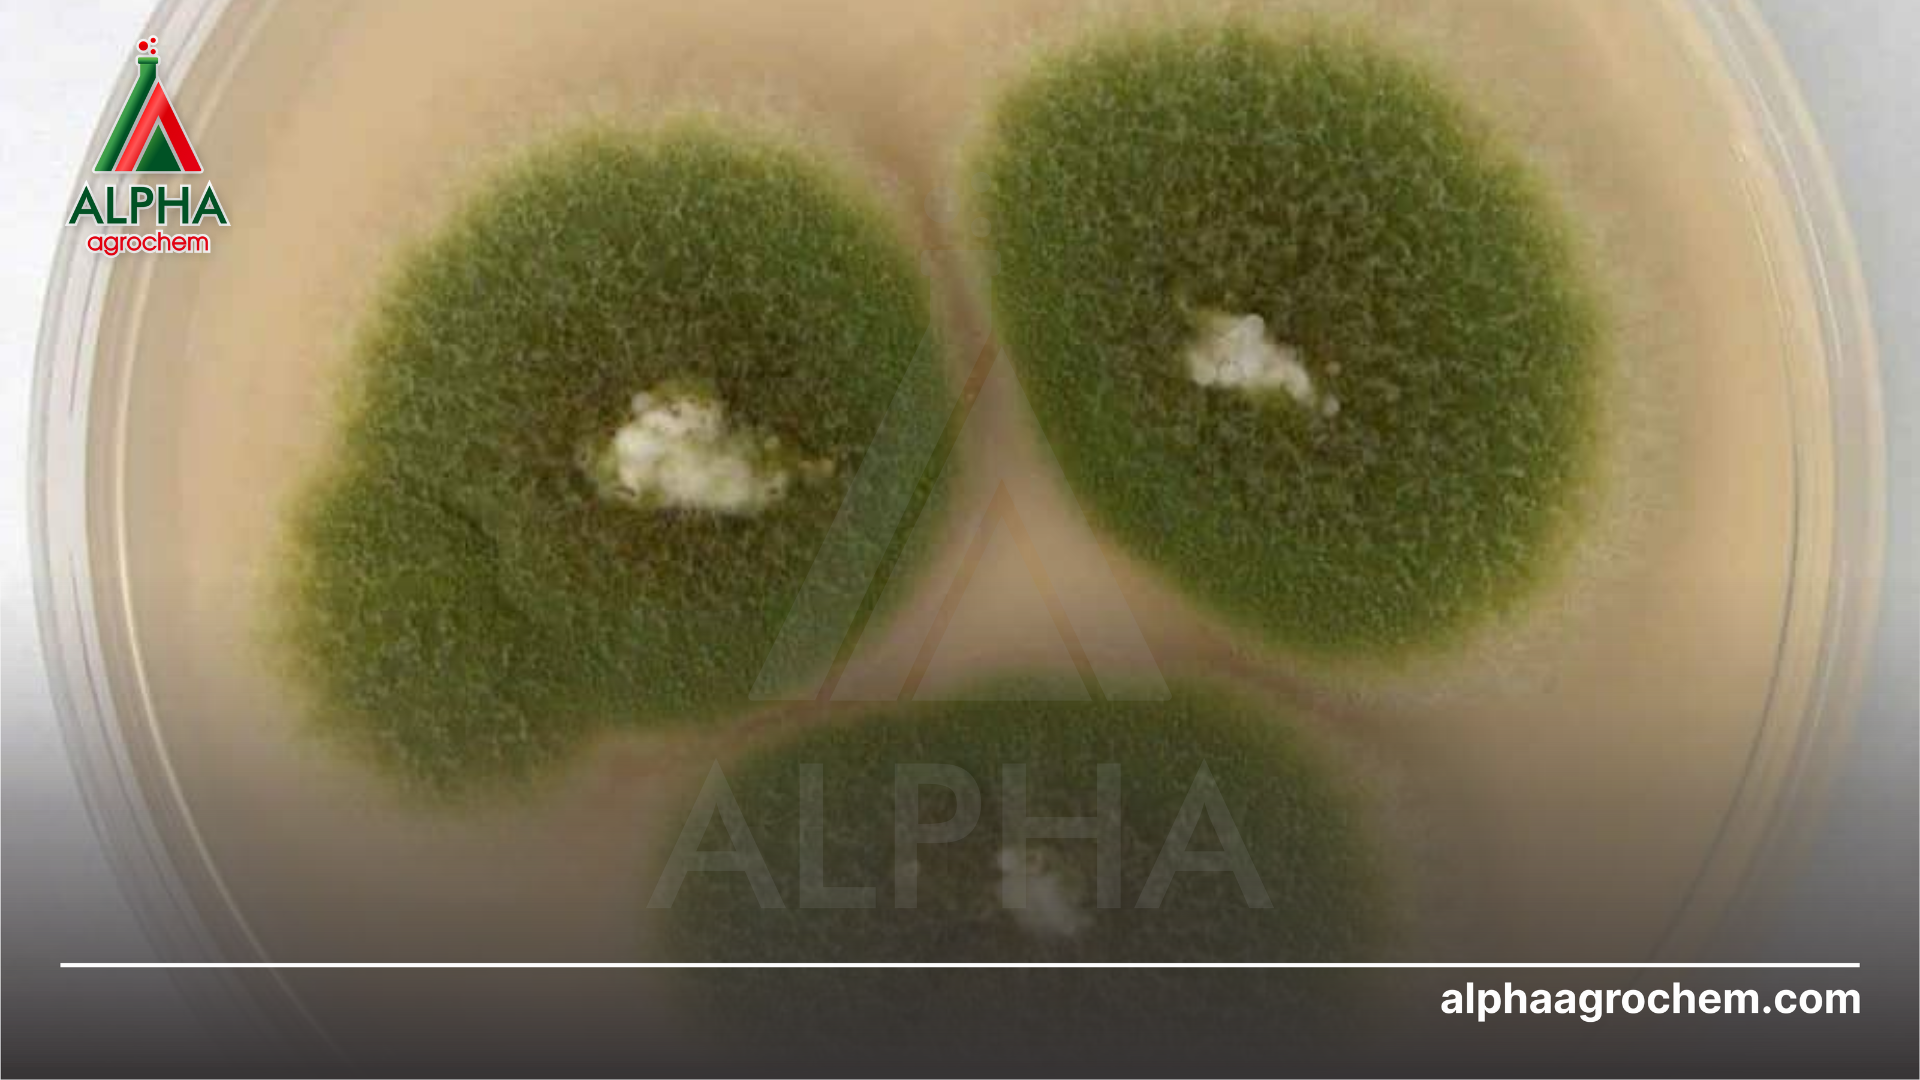
Nấm Corticium salmonicolor

Bách khoa nhà nông
Bệnh nấm hồng trên xoài và cách phòng trừ
Bệnh nấm hồng là một trong những căn bệnh phổ biến và gây hại nghiêm trọng cho cây xoài. Bệnh không chỉ làm giảm chất lượng năng suất và chất lượng quả.
1. Nguyên nhân gây bệnh nấm hồng trên xoài
Nấm Corticium salmonicolor là nguyên chính gây ra bệnh nấm hồng trên xoài. Bệnh xuất hiện chủ yếu trên vỏ cây, căn bệnh này gây ra những hiệu quả nghiêm trọng cho cây. Bà con cần xác định sớm các triệu chứng để có biện pháp phòng ngừa ngay lập tức để ngăn chặn bệnh phát triển.
2. Điều kiện phát triển bệnh nấm hồng trên xoài
- Thời tiết ẩm ướt và nhiệt đới là môi trường lý tưởng cho sự phát triển của nấm. Các cơn mưa liên tục và độ ẩm cao tạo điều kiện thuận lợi cho vi khuẩn phát triển và lây lan.
- Chất lượng đất và dưỡng chất: có thể tạo điều kiện cho nấm sinh sôi và phát triển. Các vùng đất nhiễm phèn và thoát nước kém cũng là nơi để nấm phát triển mạnh mẽ.
- Vườn cây trồng mật độ quá dày, không thông thoáng, cành xum xuê cũng là điều kiện để nấm phát triển.

3. Triệu chứng bệnh nấm hồng trên xoài
Bệnh thường xuất hiện trên khắp các bộ phận của cây:
- Lá bị thối và ố vàng: lá bị thối và chuyển sang màu vàng là những triệu chứng đầu tiên của bệnh nấm hồng. Lá có thể bị biến dạng, mất đi khả năng sinh học và khả năng hấp thụ ánh sáng.
- Trên vỏ cây: bệnh phát triển có thể xuất hiện các vết nứt trên vỏ cây. Những vết nứt này thường xuất hiện ở gần vùng đất và tạo điều kiện cho nấm xâm nhập vào thân cây, gây ra hậu quả nghiêm trọng.
- Quả xoài: thường xuất hiện những vết nứt nẻ, vỏ quả thối rữa, dần chuyển sang màu đen. Quả không phát triển bình thường, hình dạng méo mó, và sớm rụng khỏi cành, gây thiệt hại nặng nề cho người trồng.
- Những mảng mốc xuất hiện ban đầu như những đốm nhỏ, nhưng nhanh chóng lan rộng và bao phủ toàn bộ lá và quả. Chúng hút hết chất dinh dưỡng của cây, khiến lá vàng úa, rụng sớm và quả bị thối, gây thiệt hại nghiêm trọng cho năng suất.
- Cây và quả bị nhiễm bệnh nấm hồng thường phát ra một mùi hôi khó chịu, đặc biệt là khi bệnh đã phát triển thành mức độ nghiêm trọng.
- Triệu chứng cuối cùng của bệnh nấm hồng trên cây xoài là sự suy giảm năng suất và chất lượng quả. Cây trở nên yếu đuối và sinh trưởng kém hơn.

4. Biện pháp phòng trừ bệnh nấm hồng trên xoài
4.1. Biện pháp canh tác
Việc cắt bỏ và tiêu hủy ngay các bộ phận cây xoài bị nhiễm bệnh là một biện pháp cấp bách để ngăn chặn sự lây lan nhanh chóng của nấm hồng, bảo vệ những cây còn khỏe mạnh.
Để cây xoài phát triển tốt và tránh bị bệnh nấm hồng, chúng ta cần tạo ra một môi trường sống lý tưởng. Cần giảm lượng nước tưới, chọn những vị trí trồng cây có đất tơi xốp, thoát nước tốt và thông thoáng.
Vệ sinh vườn cây thường xuyên, thu gom và tiêu huỷ các cành cây bị nhiễm bệnh đem đi tiêu huỷ.
4.2. Biện pháp hoá học
Việc sử dụng thuốc bảo vệ thực vật chuyên dụng là biện pháp hữu hiệu để tiêu diệt nấm bệnh và ngăn chặn sự lây lan của bệnh nấm hồng. Tuy nhiên, cần lựa chọn loại thuốc phù hợp và tuân thủ đúng hướng dẫn sử dụng để đảm bảo hiệu quả cao nhất.
Bà con có thể tham khảo các sản phẩm BVTV tại Danh mục hoá chất.

LIÊN HỆ TƯ VẤN MIỄN PHÍ
CÔNG TY TNHH HOÁ CHẤT NÔNG NGHIỆP ALPHA
ALPHA AGROCHEMICAL CO., LTD
Hotline: 0326 80 70 50
Địa chỉ: Số 153Q Trần Hưng Đạo, Phường An Phú, Quận Ninh Kiều, Thành phố Cần Thơ, Việt Nam
Website: alphaagrochem.com
Fanpage: facebook.com/alphaagrochem




